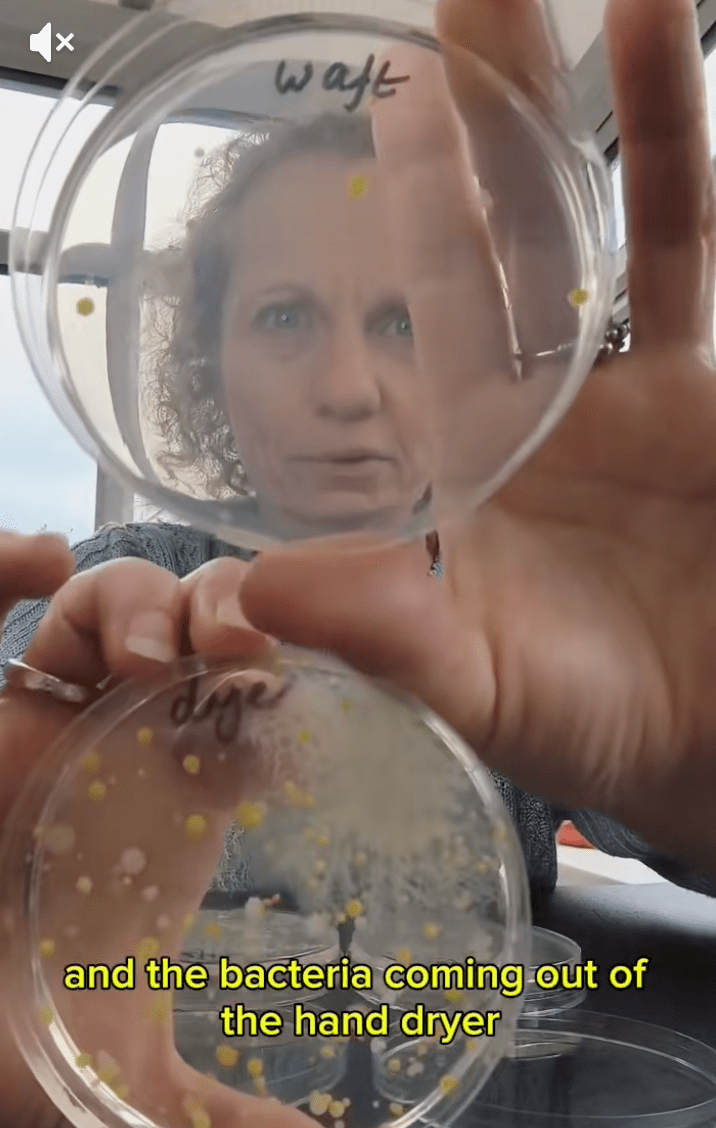
結果發現烘手機樣本長出大量細菌與真菌，而從普通空氣採集的對照組則幾乎沒有菌落。
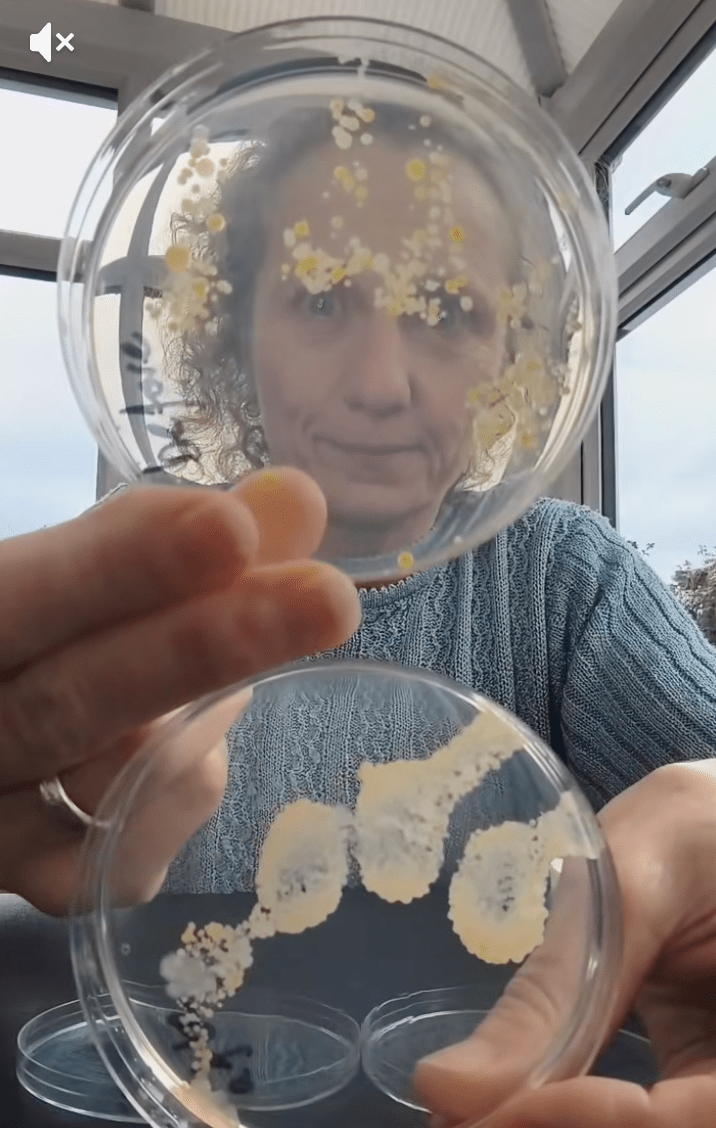
結果顯示，「洗完手後再烘乾的手」（下）含菌量僅次於烘手機出風口，菌量比未洗手前（上）還要多。

實驗揭公廁烘手機藏菌驚人 用後污糟過未洗手前 影片破千萬觀看掀熱議
英國教育機構「Devon Science」創辦人、科學家麥克拉倫(Ruth MacLaren)近日在社交平台分享一項震撼實驗,揭示公共廁所烘手機吹出的風中竟充滿細菌與真菌,經一夜培養後,培養皿上長滿多種細菌菌落,對照之下,一般空氣樣本幾乎「零生長」,結果令她直言:「這就是我不用烘手機的原因。」影片上傳後瘋傳,累積觀看次數突破一千萬,引發全球網民熱議。
據英國《Devon Live》報道,麥克拉倫將培養皿放在公廁烘手機下方收集吹出的空氣,同時以另一皿在普通空氣中揮動作對照。經過隔夜培養,結果發現烘手機樣本長出大量細菌與真菌,而對照組則幾乎沒有菌落。她後來又進行更嚴謹的對照實驗,分別採集烘手機出風口、廁所空氣、洗手前的手及洗完手後用烘手機的手,共四個樣本。結果顯示,烘手機出風口的細菌量最多,其次竟是「洗完手後再烘乾的手」,菌量比未洗手前還要多。

麥克拉倫將培養皿放在公廁烘手機下方收集吹出的空氣。TikTok@DevonScience畫面截圖(下同)

麥克拉倫將培養皿放在公廁烘手機下方收集吹出的空氣。

同時以另一皿在普通空氣中揮動作對照。
結果發現烘手機樣本長出大量細菌與真菌,而從普通空氣採集的對照組則幾乎沒有菌落。

她後來又進行更嚴謹的對照實驗,結果顯示直接從烘手機出風口採集到的細菌量最多。

她後來又進行更嚴謹的對照實驗,分別採集烘手機出風口、廁所空氣、洗手前的手及洗完手後用烘手機的手,共四個樣本。
結果顯示,「洗完手後再烘乾的手」(下)含菌量僅次於烘手機出風口,菌量比未洗手前(上)還要多。
網民驚呼「不敢再用」 也有人質疑實驗不嚴謹
影片曝光後,許多網民驚呼「以後不敢用烘手機了」,甚至有人留言:「我寧願用衣服擦手,也不想被吹一臉細菌。」另有網友質疑實驗未足科學,指出廁所烘手機的採集樣本不夠多,並建議同時測試紙巾擦手或自然風乾的效果。
部分醫學專家則呼籲公眾毋須過度恐慌,指無論使用紙巾或烘手機,只要洗手步驟確實、能徹底烘乾或擦乾,手部細菌量便可大幅降低。真正關鍵在於「洗手是否正確」,而非僅限於烘手機或紙巾孰優孰劣。
雖然科學界對烘手機是否會二次污染仍有爭議,但麥克拉倫的實驗無疑再度喚起公眾對公廁衛生的關注,也讓不少人重新審視每日看似微不足道的洗手習慣。
---------------------------------------------
>>>星島網WhatsApp爆料熱線(416)6775679,爆料一經錄用,薄酬致意。
>>>立即瀏覽【生活百答】欄目:新移民抵埗攻略,老華僑也未必知道的事,移民、工作、居住、食玩買、交通、報稅、銀行、福利、生育、教育。
>>>星島網WhatsApp爆料熱線(416)6775679,爆料一經錄用,薄酬致意。
>>>立即瀏覽【生活百答】欄目:新移民抵埗攻略,老華僑也未必知道的事,移民、工作、居住、食玩買、交通、報稅、銀行、福利、生育、教育。
×
